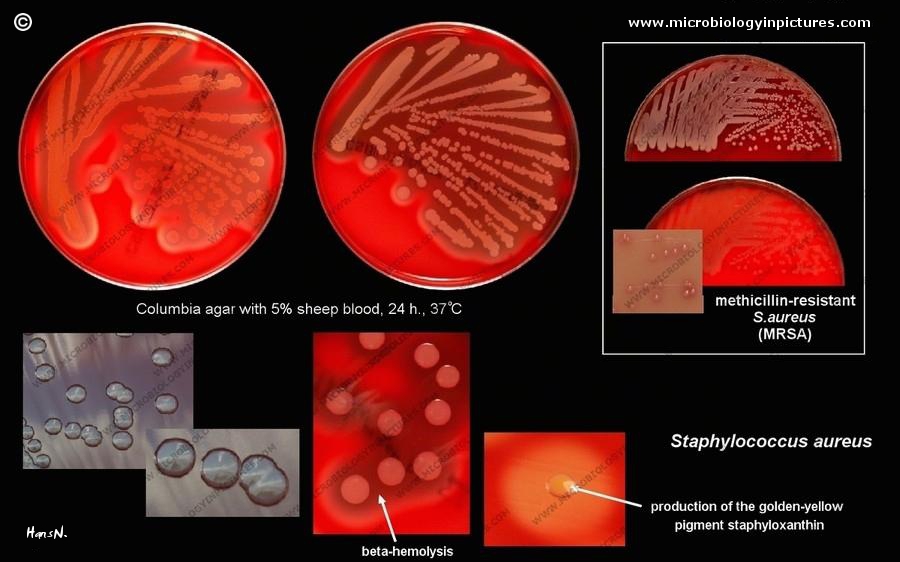

I’m not even going to go into the whole antibiotic resistance thing which apparently is so bad at this point that they are handing out loaded guns in Medical school according to my youngest son Benjamin who goes to MSG (Note: It’s actually MCG, now officially GRU, Georgia Regents University in Augusta but I am guessing they will change the name again by the time this article is published and it will be renamed after the food additive and owned by Monsanto or Dow Chemical) . Along with a cheap diploma and $400,000 in student loan debt, med students are being told two critical last minute instructions: 1) If your patient dies and starts to get up or have “zombie eyes” finish them off and make sure its a “double tap” and 2) If they ALL start to get up, save the last chamber for yourself. You dont want what they have. Bottomline: Whatever little bugs infect the brains of the Undead are some mean microbial bastards and much like fire ants, the Viet Cong, and the alien bugs in Starship Troopers they all work together to achieve their ultimate goal of world domination. In other words, Hitler and Pol Pot were insignificant little pisshers compared to Ebola, MERSA and rapid spreading flesh-eating bacteria.
.
I would tell you to view Dr. Oz and his terrifying apocryphal interview on Oprah about the “triangle of death” but I wont. He essentially says if you pull out a nose hair (I do) or squeeze a zit anywhere near your nose, forehead, or eyes( I do) well, you’re dead. This is apparently EXACTLY what most bacteria have been waiting for… to be set free from their encapsulated Lex Luther lairs to rock climb through your nasal passages right into your brain. Mess with that juicy whitehead right between your eyes and you might as well put your legal affairs in order and buy that Neptune Society Cremation Package deal on Groupon like I just did. While you’re at it make sure to select the Viking Style Funeral Pyre ceremony and ask that it be “magma hot” because that’s what it will take to kill all the one cell organisms feasting on your cerebellum like rabid wild jackals.
.
Look, I realize this is all too much reality for many of you. Most people prefer to live in deep denial. Freud said as much. Like the Brits, the vast majority of English speakers consider themselves “Masters of the Universe” and “proper” citizens while at the same time failing to ever see a competent dental hygienist. Yep, you got it. It was Pyorrhea, H. Pylori bacteria and astonishingly bad breath that took down the proud British Empire and not rampant colonialism or Princess Diana.
.
With summer approaching I want to give you one last warning which I’m quite sure will fall on deaf ears. It’s about water. Dont drink it. None of it is fit. Sure we need it to live, but do you really want to survive only to turn into the kind of zombie man-beast in “I Am Legend”? Even Will Smith couldn’t defeat them and he’s pretty damn tough. Worse yet, on top of pathogens that are naturally found in water, humans also introduce their own share of germs when they slip into a swimming pool or hot tub. “The average bather has about a tenth of a gram of feces in his gluteal fold, which is a nice way of saying butt crack.” Dr. Gerba of the CDC goes on to say, “That means with five people you have a tablespoon of poop in the hot tub.” That is correct. A super high official at the CDC and a world renowned specialist in Infectious Diseases actually says “butt crack” and “tablespoon of poop”.